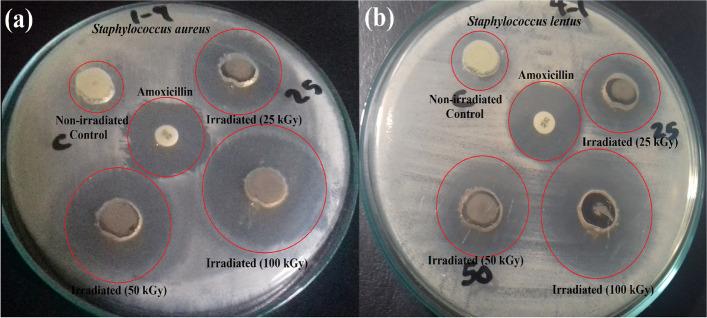
https://cdn.ncbi.nlm.nih.gov/pmc/blobs/3513/10521429/1d0899298144/12866_2023_3016_Fig4_HTML.jpg

经伽马射线辐照的新型纳米复合材料具有潜在的抗菌、抗生物膜和光催化性能,用于增强消毒应用,并研究了其反应机制。
Potential antibacterial, antibiofilm, and photocatalytic performance of gamma-irradiated novel nanocomposite for enhanced disinfection applications with an investigated reaction mechanism.
机构信息
Drug Radiation Research Department, National Centre for Radiation Research and Technology (NCRRT), Egyptian Atomic Energy Authority (EAEA), Cairo, Egypt.
Center for Nanotechnology (CNT), School of Engineering and Applied Science, Nile University, Sheikh Zayed, Giza, 16453, Egypt.
出版信息
BMC Microbiol. 2023 Sep 26;23(1):270. doi: 10.1186/s12866-023-03016-3.
BACKGROUND
Water scarcity is now a global challenge due to the population growth and the limited amount of available potable water. In addition, modern industrialization, and microbial pathogenesis is resulting in water pollution on a large scale.
METHODS
In the present study, reusable CoNiFeO/SiO/TiO composite matrix was incorporated with CdS NPs to develop an efficient photocatalyst, and antimicrobial agents for wastewater treatment, and disinfection purpose. The antibacterial performance of the gamma-irradiated samples was evaluated against various types of Gram-positive bacteria using ZOI, MIC, antibiofilm, and effect of UV-exposure. Antibacterial reaction mechanism was assessed by bacterial membrane leakage assay, and SEM imaging. In addition, their photocatalytic efficiency was tested against MB cationic dye as a typical water organic pollutant.
RESULTS
Our results showed that, the formed CdS NPs were uniformly distributed onto the surface of the nanocomposite matrix. While, the resulted CdS-based nanocomposite possessed an average particle size of nearly 90.6 nm. The antibacterial performance of the prepared nanocomposite was significantly increased after activation with gamma and UV irradiations. The improved antibacterial performance was mainly due to the synergistic effect of both TiO and CdS NPs; whereas, the highest photocatalytic efficiency of MB removal was exhibited in alkaline media due to the electrostatic attraction between the cationic MB and the negatively-charged samples. In addition, the constructed heterojunction enabled better charge separation and increased the lifetime of the photogenerated charge carriers.
CONCLUSION
Our results can pave the way towards the development of efficient photocatalysts for wastewater treatment and promising antibacterial agents for disinfection applications.
背景
由于人口增长和可用饮用水量有限,水资源短缺现在是一个全球性的挑战。此外,现代工业化和微生物发病机制导致大规模的水污染。
方法
在本研究中,将可重复使用的 CoNiFeO/SiO2/TiO2 复合基质与 CdS NPs 结合,开发出一种高效的光催化剂,用于处理废水和消毒。使用 ZOI、MIC、抗生物膜和 UV 暴露效应评估辐照样品对各种类型革兰氏阳性细菌的抗菌性能。通过细菌膜渗漏测定法和 SEM 成像评估抗菌反应机制。此外,还测试了它们对 MB 阳离子染料作为典型水有机污染物的光催化效率。
结果
结果表明,形成的 CdS NPs 均匀分布在纳米复合材料基质的表面上。而基于 CdS 的纳米复合材料具有近 90.6nm 的平均粒径。经过伽马和紫外线辐照激活后,制备的纳米复合材料的抗菌性能显著提高。抗菌性能的提高主要归因于 TiO2 和 CdS NPs 的协同作用;而在碱性介质中,MB 去除的光催化效率最高,这是由于阳离子 MB 和带负电荷的样品之间的静电吸引。此外,构建的异质结能够更好地分离电荷并增加光生载流子的寿命。
结论
我们的结果为开发用于废水处理的高效光催化剂和用于消毒的有前途的抗菌剂铺平了道路。